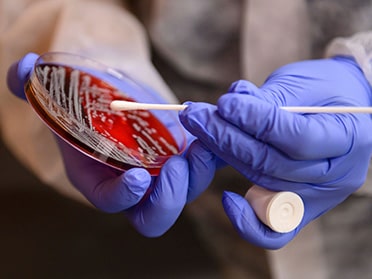
In a laboratory used by B.S. in Medical Laboratory Science students at Georgia Southern, two gloved hands swab a petri dish to take a sample

Learn to solve medical mysteries and help patients stay on the road to health with a Bachelor of Science (B.S.) in Medical Laboratory Science from Georgia Southern University.
Locations
- Armstrong Campus (In Person)
- Online
Why Earn a Bachelor’s in Medical Laboratory Science at Georgia Southern?
- Join the largest medical laboratory science program in Georgia.
- 84%: Percentage of Georgia Southern alums who passed the American Society of Clinical Pathology (ASCP) or American Medical Technologists (AMT) exam within a year of graduation — 10% above the national rate.
- Already working? Jump-start your career in one of our online-only tracks.
- 100% of students found employment within six months of graduation (2020-2022).
- 124 credit hours to completion.
Before doctors can treat a disease, they need to diagnose it. Laboratory scientists play a critical behind-the-scenes role in helping physicians shape health care plans for their patients. Whether diagnosing conditions like cancer or diabetes, screening for drug or alcohol use, or even detecting whether a patient has had a heart attack, clinical lab scientists assist with improving care outcomes, monitoring chronic illnesses and identifying population health trends.
In the B.S. in Medical Laboratory Science degree program at Georgia Southern, learn techniques you’ll put to work every day in the field analyzing blood, bodily fluid and more samples, getting hands-on experience with biomedical instrumentation and other technologies in the process. You’ll also learn the science of hematology, microbiology, immunology, clinical chemistry and urinalysis, so you’ll understand your profession at a cellular level (literally).
If you’re already a certified lab tech or are a South Carolina resident with a B.S. in Biology or Chemistry and currently work in a hospital laboratory setting, our online-only programs get you on a path to more responsibility and higher pay in just four semesters.
Ready to Apply?
What Can You Do With a Bachelor’s in Medical Laboratory Science?
“We’ll need a sample.” Every time a doctor tells that to a patient, a medical laboratory scientist is on the other end, either helping to offer a diagnosis or supporting a treatment plan’s effectiveness. And as our population gets older, the health care field will see elevated demand for qualified laboratory scientists.
Where our graduates work:
- American Red Cross
- Cancer Treatment Centers of America
- Emory Healthcare
- Quest Diagnostics
- United States Department of Veterans Affairs
What our graduates do:
- Medical laboratory scientist
- Clinical laboratory scientist
- Medical Technologist
- Medical technician
- Pathologist
What You’ll Learn
Accurate results are just part of laboratory science. You’ll also consult with physicians, record and analyze data, and evaluate and interpret your findings. At Georgia Southern, combine coursework with the various aspects of lab science — including instruction in general laboratory procedures and skills, laboratory mathematics, medical computer applications and interpersonal communication.
See the CurriculumTracks
No matter if you’re just starting your college journey or pursuing a second bachelor’s degree, our medical laboratory science program has a track that fits your needs.
Traditional
This track is designed for entering first-year and transfer students and students returning for a second bachelor’s degree. Graduate prepared to sit for the American Society of Clinical Pathology Board exams.
Online Career Ladder
Through this track, certified medical laboratory technicians already employed at an approved clinical site can complete their bachelor’s in just four semesters. The degree qualifies graduates for education, supervision and management positions.
Online Fast Track
Specialize your scientific background in just four semesters through this online-only program. It is open to students with B.S. degrees in biology, chemistry or other related fields. You must be employed by a hospital laboratory unless you are a South Carolina resident.
Build Your Experience
Every one of our 2020–2022 graduates landed work within six months of completing their degrees. Along with our program’s impressive pass rates and extensive history, employers know Georgia Southern students enter the health care field with the experience they need to accurately deliver results and contribute to innovation.

Real-World Work
The best place to see how a laboratory works is in a working lab. Before graduating, you’ll complete a practicum, during which you’ll gain clinical experience in microbiology, chemistry, immunohematology, hematology, coagulation, immunology, urinalysis, phlebotomy and molecular diagnostic testing.

Student Organizations
Build your network and take a closer look at the field by participating in student groups, including the Medical Laboratory Science Club, the American Society for Clinical Laboratory Science, the Institute for Healthcare Improvement (IHI) and the Health Sciences Student Association (HSSA).
ASCP Student Associate Membership
Become an ASCP Student Associate member if you intend to meet the ASCP Board of Registry’s eligibility requirements for certification. You’ll be eligible for ASCP Associate membership once certified by the ASCP Board of Registry. Please note that your application must be signed by your program director.
Want to Learn More?
Explore essential information about our B.S. in Medical Laboratory Science program, including application details, accreditation status, and licensing disclosures. Gain insight into the program’s credibility and requirements to help you start your journey toward success with the knowledge you need.
We accept applications for the B.S. in Medical Laboratory Science program from Nov. 15 to March 1.
Late applications will be considered on a case-by-case basis. Qualified applicants who meet the March 1 deadline will be granted priority over applications received after the initial deadline. Certain programs may continue to review applications after the deadline until the program’s capacity is met.
Additionally, applicants may need to meet program-specific requirements.
- Applicants must be accepted by Georgia Southern University.
- Apply as a student seeking a B.S. degree.
- If you have a B.S. degree, apply as a Post-Bac seeking a degree.
- Please choose the Armstrong Campus even if you are interested in the online program.
- Please choose a degree in health sciences. (If accepted into the program, this will then change to medical laboratory sciences.)
- Applicants must apply via and pay for the Allied Health Centralized Application Service (AHCAS) Application.
- Applicants must have a cumulative GPA of 2.5 or greater overall and in all sciences.
- All Core courses (including Areas A, D and F) must be completed with a grade of “C” or better prior to program admission.
- Applicants who have applied for grade forgiveness or academic renewal will have their transcripts evaluated on a case-by-case basis in accordance with University policies.
- Other applicants who do not meet the minimum criteria may be considered under special circumstances.
Applicants most complete two Confidential Reference Forms.
To apply for Georgia Southern scholarships, accepted students must log in to MyGeorgiaSouthern and click the MyScholarships link under the “Services” App.
SDS Grant
Students majoring in medical laboratory sciences who represent an economically disadvantaged background, as defined by the U.S. Department of Health Resources and Service Administration (HRSA), are eligible to apply for the Scholarships for Disadvantaged Students program. The program is designed to increase diversity in the health professions and nursing workforce by offering awards to institutions that provide scholarships to students from disadvantaged backgrounds who are enrolled full time in a health profession or nursing program.
The medical laboratory science program offers two online options: a post-baccalaureate program for South Carolina residents holding a B.S. in Biology, Chemistry or related science and a career-track option for certified medical laboratory technicians (MLTs) who want to pursue a B.S. in Medical Laboratory Science.
You can complete the career-track program in just four semesters — meaning you can quickly find the additional job opportunities and higher pay that a B.S. delivers. You’ll gain clinical experience at a location we identify in conjunction with the South Carolina Hospital Association.
You can also complete the post-baccalaureate program in four semesters. You’ll need to maintain training support at an approved clinical facility while a student in this program.
About Our Online ProgramsThe Medical Laboratory Science program at Georgia Southern University is accredited by the National Accrediting Agency for Clinical Laboratory Sciences (5600 N. River Rd., Suite 720, Rosemont, IL 60018-5119. Telephone, 773-714-8880; fax, 773-714-8886; email, info@naacls.org).
Since 1990, the program has received continuing accreditation by the National Accrediting Agency for Clinical Laboratory Sciences (NAACLS).
National Board of Certification Examination Pass Rate
| Class of: | # of Graduates Taking Exam | Program % Who Passed the ASCP or AMT Within the First Year of Graduation | National # Who Passed Within the First Year of Graduation |
| 2022 | 20 | 84.2% | 72.45% |
| 2023 | 15 | 78% | 74.3% |
| 2024 | 16 | 84% | 75.54% |
| 2025 | 11 | 100% | 75.99% |
*Data for Class of 2025 is incomplete due to Dec 2025 graduation
Employment Rate
| Class of: | Total # of Graduates | Secured Initial Employment or Continued Education Six Months Post-Graduation (Traditional) | Secured Initial Employment or Continued Education Six Months Post-Graduation (Online) |
| 2022 | 24 | 100% | 100% |
| 2023 | 15 (online) | Not applicable* | 94% |
| 2024 | 33 | 83.3% | 100% |
| 2025 | 25 | 50% | 100% |
*Data for Class of 2025 is incomplete due to Dec 2025 graduation
Graduation Rates
| Class | Students beginning Second half of program | Students Graduating | Attrition Rate | Graduation Rate |
| 2022 | 28 | 28 | 0% | 100% |
| 2023 | 16 | 15 | 6% | 94% |
| 2024 | 34 | 33 | 3% | 97% |
| 2025 | 25 | 25 | 0% | 100% |
*Data for Class of 2025 is incomplete due to Dec 2025 graduation
The Department of Clinical Sciences anticipates that graduates of this program will seek the following professional certifications: American Society for Clinical Pathologists (ASCP) Certification and laboratory personnel licensure.
The Department of Clinical Sciences has determined that the required classes and educational activities of this online Career Ladder, Fast Track and MLT-MLS academic program will qualify a graduate of this program to take the exam for ASCP Certification in all 50 United States. The Department has not determined whether this program satisfies the requirements of all states and territories for laboratory personnel licensure. Visit the ASCP Board of Certification and the American Society for Clinical Laboratory Science to determine the requirements of your state or territory.
Related Programs

Take the Next Step
You can play a vital role in diagnosing disease and helping patients begin the road to recovery in Georgia Southern’s medical laboratory science program. Learn more today.



